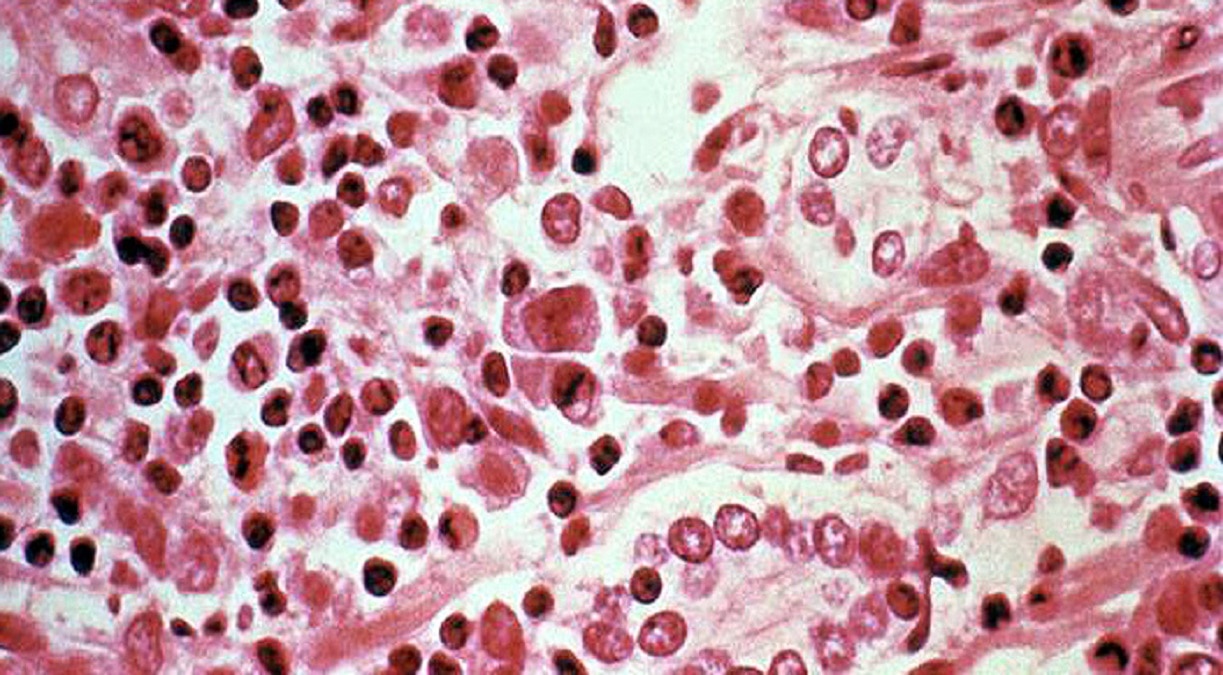
आंध्र प्रदेश में फैली अज्ञात बीमारी

आंध्र प्रदेश के अस्पतालों में फैली अज्ञात बीमारी, चपेट में 600 से ज्यादा लोग
कोरोना का कहर अभी खत्म नहीं हुआ कि आंध्र प्रदेश के एलुरु शहर में अस्पतालों में एक रहस्यमयी बीमारी सामने आई है. यहां बड़ी संख्या में लोगों को अस्पतालों में भर्ती कराया गया है. इस बीमारी के बारे में केंद्रीय स्वास्थ्य सचिव राजेश भूषण और संयुक्त सचिव लव अग्रवाल ने शनिवार को उपराष्ट्रपति एम वेंकैया नायडू को भी जानकारी दी है. (सभी तस्वीरें- सांकेतिक)
दरअसल, आंध्र प्रदेश के एलुरु में इस रहस्यमय बीमारी से 600 से ज्यादा लोग बीमार पड़ गए. बताया गया है कि उन्हें चक्कर आ रहा था. इसके अलावा वे सिरदर्द और उल्टी से पीड़ित थे. इस बारे में केंद्रीय स्वास्थ्य मंत्री हर्षवर्धन ने उपराष्ट्रपति एम वेंकैया नायडू से मिलने के बाद 8 दिसंबर को चिकित्सा विशेषज्ञों की तीन सदस्यीय टीम को एलुरु भेजा था.
एक आधिकारिक बयान में कहा गया है कि स्वास्थ्य सचिव ने उपराष्ट्रपति को एलुरु के प्रभावित क्षेत्रों का दौरा करने वाली केंद्रीय टीम के प्रारंभिक निष्कर्षों की जानकारी दी है. अधिकारी ने कहा कि केंद्रीय टीम के दिल्ली लौटने पर एक विस्तृत रिपोर्ट तैयार की जाएगी और उसके अनुसार आवश्यक सलाह जारी की जाएगी.